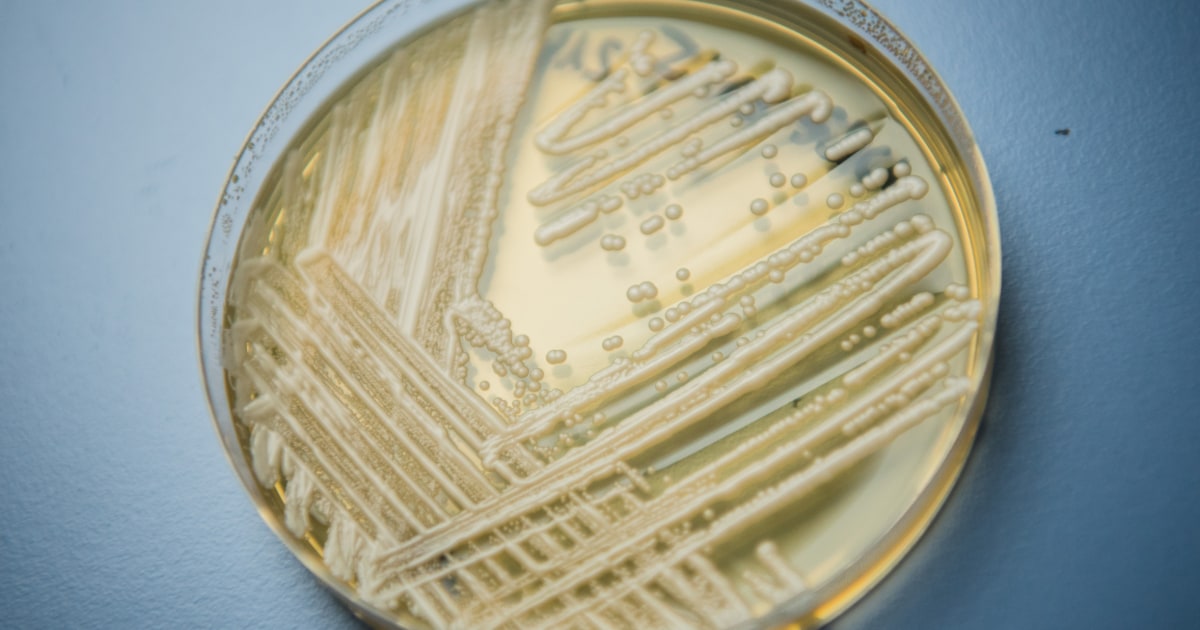
Featured image for "Deadly C. auris Fungus Outbreak Confirmed in Washington State"

Hospital-Specific Phage Cocktail Developed for Enterobacter Cloacae Infections
Researchers designed a hospital-specific phage cocktail, Entelli-02, targeting Enterobacter cloacae complex to combat antimicrobial resistance, demonstrating broad efficacy in vitro, in vivo, and on clinical isolates, with potential for rapid clinical deployment.